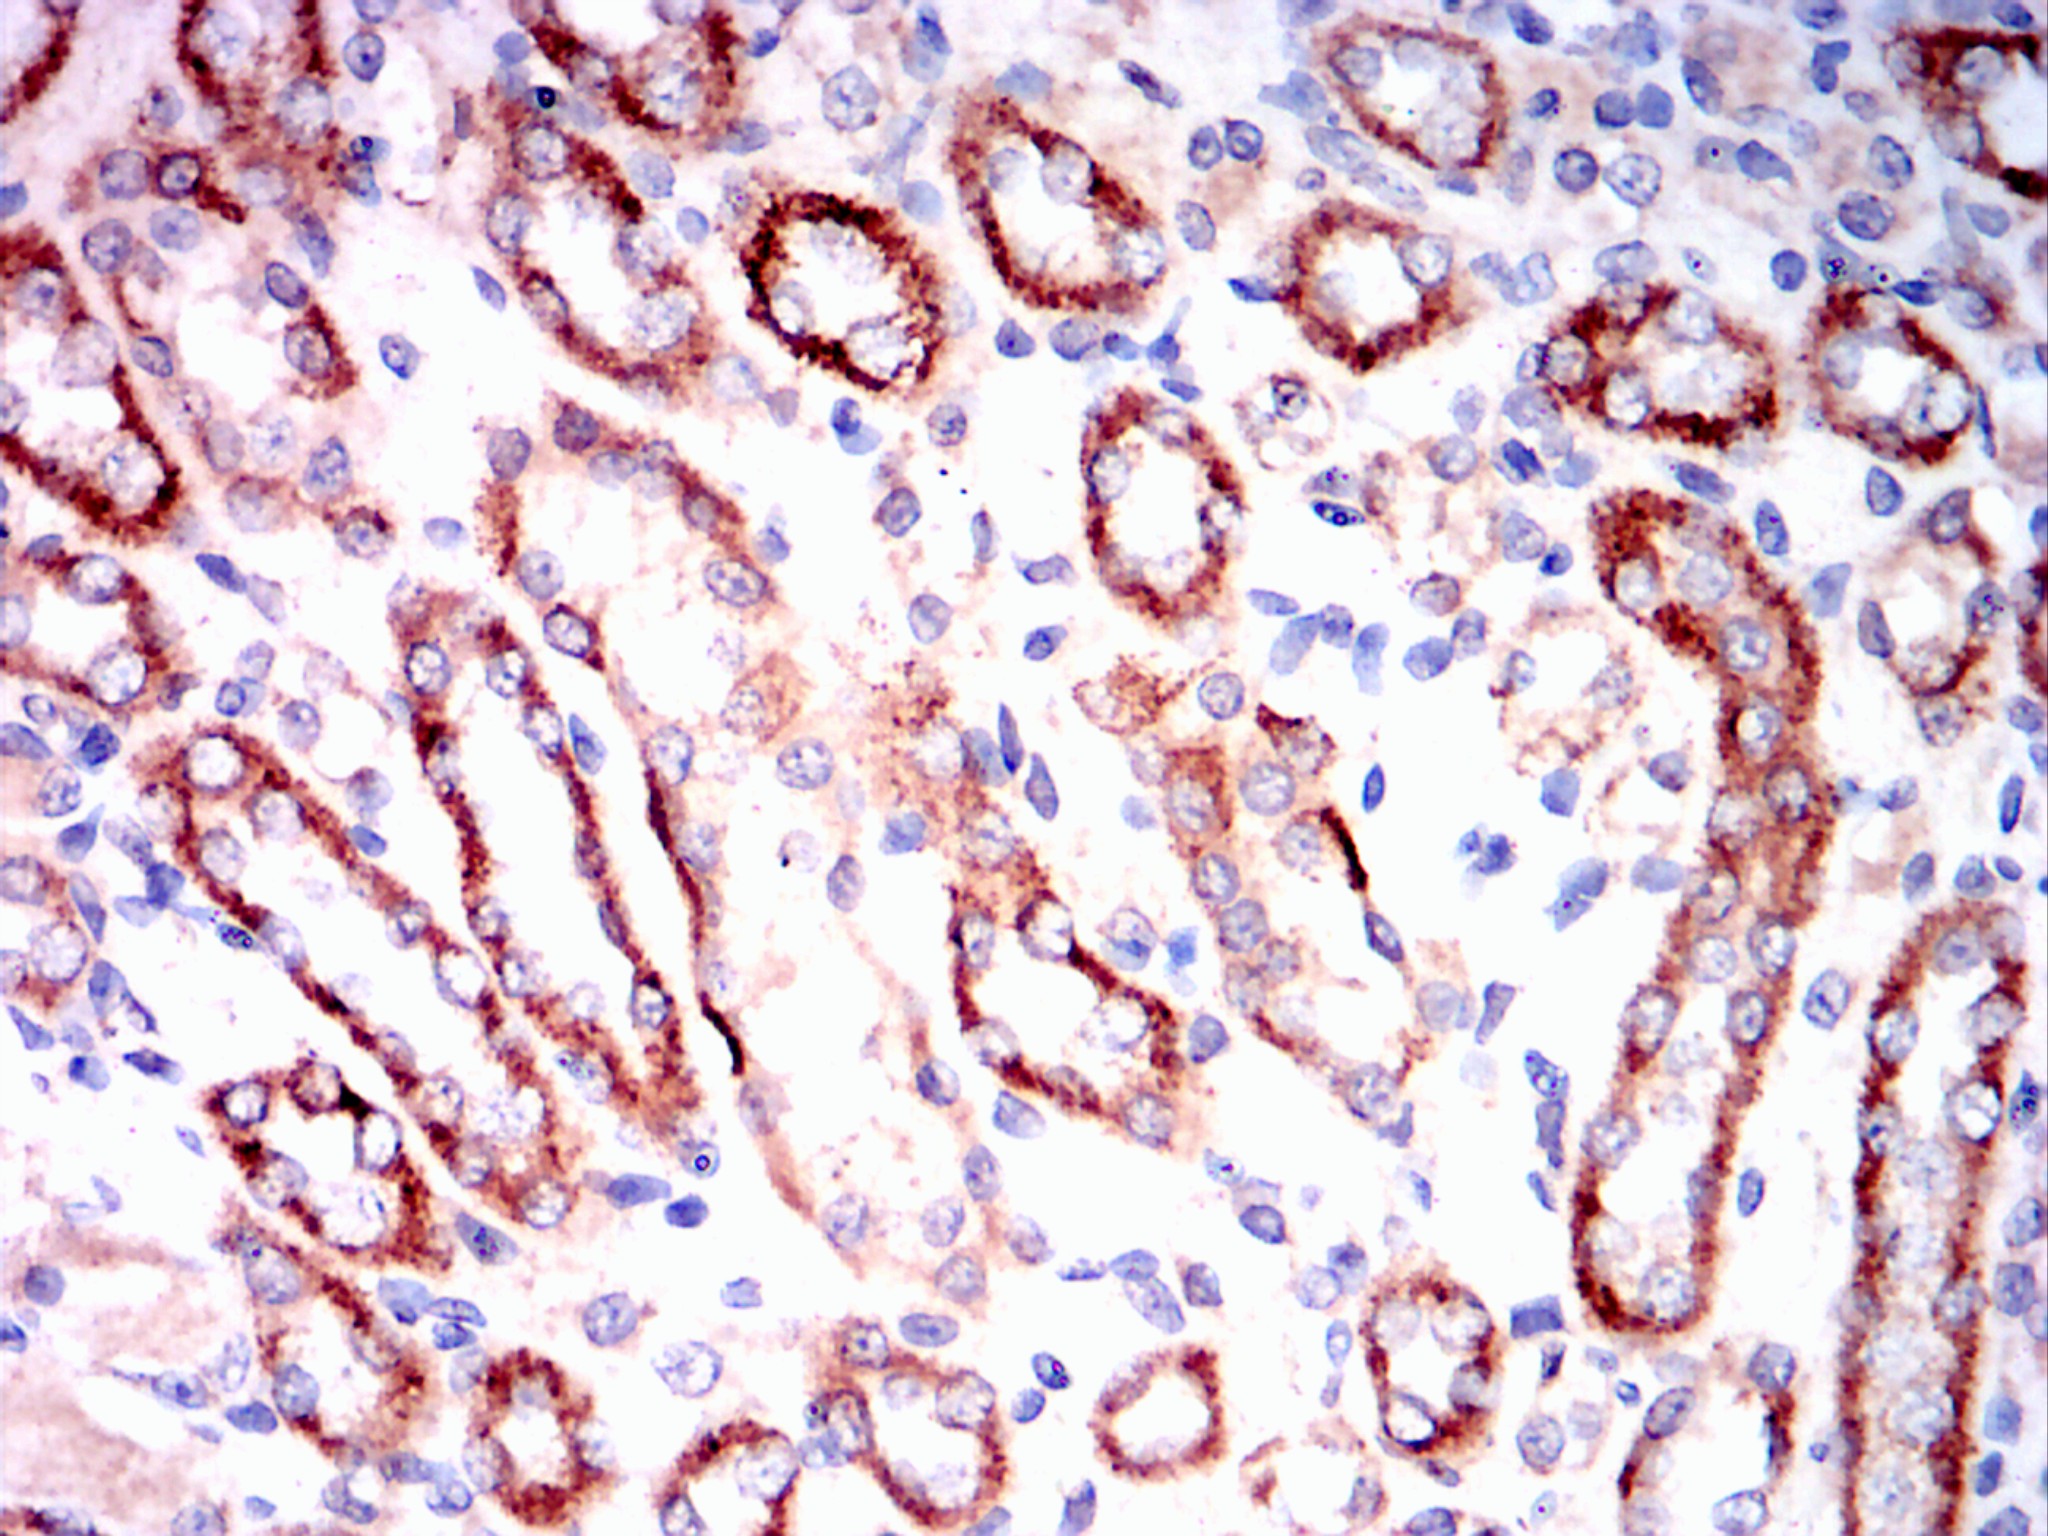

-
分类: 科研抗体货号: 20178别名: LPP应用: WB,IHC,IF反应种属: Human,Mouse,Monkey,Hamster
-
分类: 科研抗体货号: 20156别名: BNP; NPPB应用: IHC反应种属: Human
-
分类: 科研抗体货号: 20138别名: IGF1R, IGF1R-Beta应用: IHC反应种属: Human
-
分类: 科研抗体货号: 20176别名: API4; EPR-1; BIRC5应用:反应种属: Human
-
分类: 科研抗体货号: 20155别名: RACE应用: WB,IHC,IF反应种属: Human,Mouse
-
分类: 科研抗体货号: 20137别名: Human P16应用: IHC反应种属: Human
-
分类: 科研抗体货号: 20174别名: IKBKE应用: FCM,IHC反应种属: Human
-
分类: 科研抗体货号: 20154别名: NEF; S100; S100beta应用: IHC反应种属: Human
-
分类: 科研抗体货号: 20136别名: RSK; HU-1; RSK1; MAPKAPK1A; RPS6KA1应用: IHC反应种属: Human
-
分类: 科研抗体货号: 20172别名: APS; PSA; hK3; KLK2A1; KLK3应用: IHC,FCM反应种属: Human

鄂公网安备42018502007531号
鄂公网安备42018502007531号

